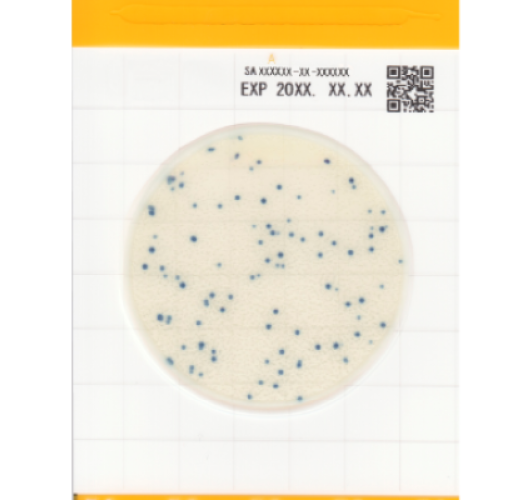
Стафилококк золотистый - Easy Plate SA

Стафилококк золотистый - Easy Plate SA
Easy Plate SA — это удобная пластина со средой для обнаружения Стафилококка золотистого (Staphylococcus aureus).
Содержащая хромогенный субстрат, который образует легко различимые ярко окрашенные голубые колонии, что позволяет легко идентифицировать и количественно оценить Staphylococcus aureus. По сравнению с агаром Байреда-Паркера и агаром с маннитовой солью и яичным желтком, время инкубации с Easy Plate SA сократилось до 24±1 часа. Easy Plate SA также содержит ингибиторы, которые подавляют рост микроорганизмов, отличных от Staphylococcus aureus, но если эти микроорганизмы развиваются, колонии можно легко отличить по цвету от розового до красно-фиолетового.
Не требующая подготовки или стерилизации.
Время инкубации: 24 ± 1 час
Температура инкубации: 35 или 37±1℃
Температура хранения: 2 - 8℃
Срок годности: 18 месяцев
Упаковка: 100 тестов (25 тестов х 4 пакета)